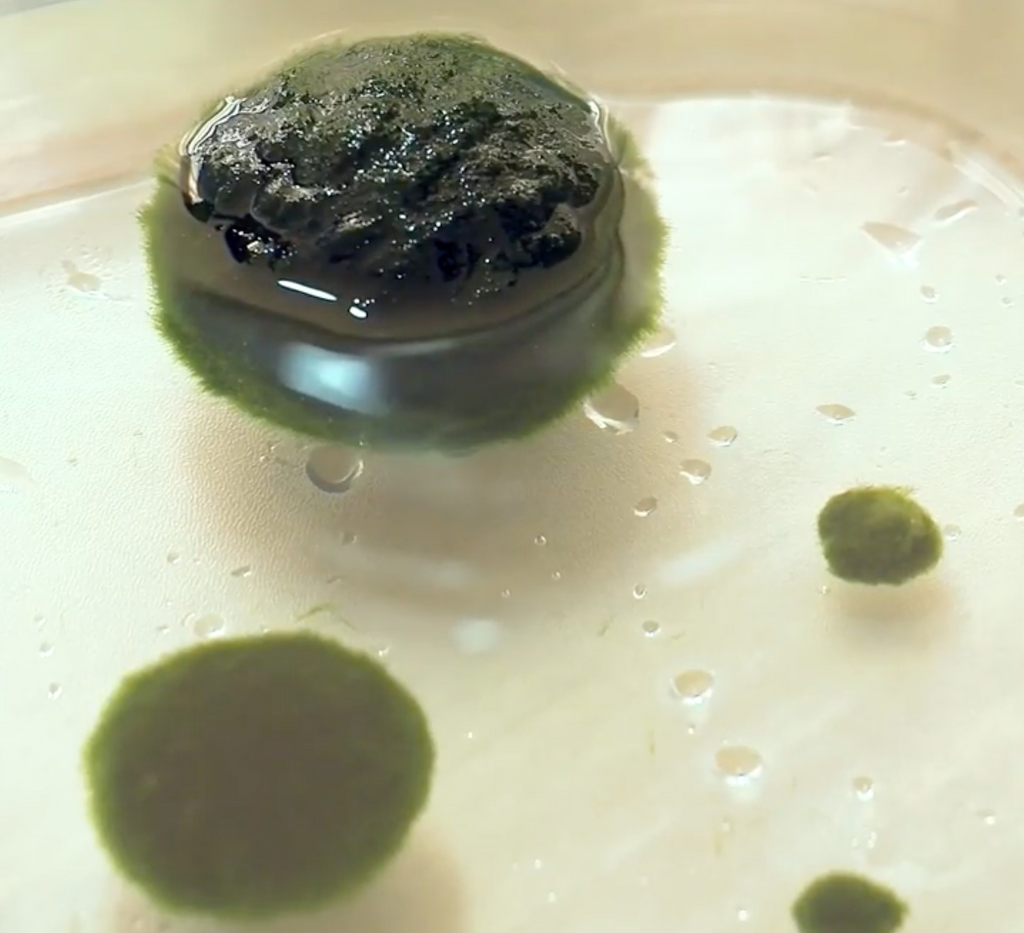
Marimo Moss Ball Ecosistema

Marimo Moss Ball Ecosistema
Detalles
Marimo
Esta esfera verde y aterciopelada no es ni un musgo ni una planta, sino una especie de alga verde conocida como Aegagropila Linnaei; el cual se encuentra en su estado natural en algunos lagos en Japón. El apodo “Marimo” se traduce del japonés como “planta de agua que es como una pelota saltarina”. Esta traducción es muy acertada, ya que produce burbujas de oxígeno que lo hacen flotar haciéndola subir y bajar como si estuviera saltando!
¿Dónde colocarlo?
Básicamente le viene bien casi cualquier lugar; solo asegúrate que reciba un poco de luz (indirecta) NO SOL, ya que aprecian la luz baja a media, así que mantenlos fuera del alcance de la luz directa.
Mantenimiento
Se recomienda rodar ligeramente el Marimo en tus manos cada vez que hagas un cambio de agua para que no pierda su forma. Además darle la vuelta de vez en cuando para que tengan acceso a la luz por todas sus partes y no comiencen a oscurecerse. En cada cambio de agua (cada 15 días) con agua de grifo a temperatura ambiente. El agua no debe haber pasado por ninguna especie de filtro por etapas, de ozono, etc.). Lava el recipiente, piedras y decoración (solo con agua) con ayuda de los dedos. Lo anterior para prevenir la aparición de algas y que tu Marimo esté más saludable.
Los Marimo son usados como ¨pet plant¨ y como regalo; poniéndolos en recipientes de vidrio junto con piedras decorativas, conchas de caracol, etc. También para usar como decoración para el hogar, ya que dan un aspecto natural y acogedor. Además se regalan como símbolo de amistad y amor eterno, ya que pueden vivir más de 300 años superando así las generaciones!
Se encuentra en su estado natural en algunos lagos en Japón. Los comercializados por nosotros son cultivados; manteniendo así el respeto por los ecosistemas naturales y ambientes salvajes, así que puedes tener los que quieras con completa tranquilidad.
¡Si deseas una “planta de interior” poco exigente o un pequeño compañero, no encontrarás nada más fácil de cuidar!
Cuidado y mantenimiento
Bromelias
Riego 1 vez por semana
Fertilizante semanal
Colocarlas en luz interior
Evitar sol directo
Tillandsias
Sumergir 5 min cada 8 días
Mantener las hojas limpias
Ubicarlas en luz interior
Evitar sol directo
Tips:
Usa agua reposada o de filtro
Mantener sus hojas libres de polvo
Hidrata las hojas de tus plantas
Fertilizante una vez por semana
Tamaño
Bromelias:
Talla S: 20 a 30 cm
Talla M: 30 a 45 cm
Talla L: 45 a 60 cm
Tillandsias:
Talla S: 5 a 15 cm
Talla M: 15 a 25 cm
Talla L: 25 a 40 cm
Especial: Autosuficiente, no necesita tierra
¿Tienes dudas sobre tu pedido?
Escríbenos al 322 325 4099, ¡con gusto te ayudamos!